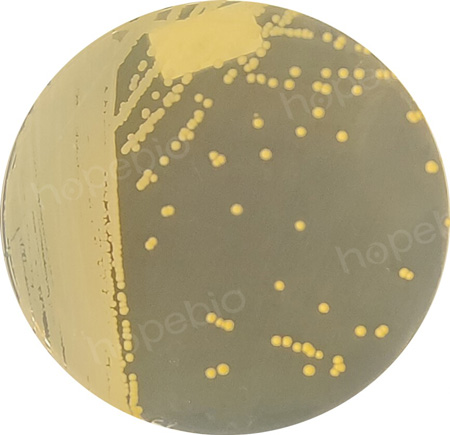

海博微信公众号
海博微信公众号
 海博天猫旗舰店
海博天猫旗舰店


 海博微信公众号
海博微信公众号
 海博天猫旗舰店
海博天猫旗舰店




引言
当我们结束一天的忙碌,卸下疲惫准备入睡时,很少有人会意识到:陪伴我们进入梦乡的,除了柔软的被褥,还有数以亿计的细菌。这些细菌藏匿在我们的身体表面、日常接触的物品上,在夜间密闭、温暖的环境中悄然繁殖,不仅可能影响睡眠质量,更可能成为健康隐患。
人体本身是一个庞大的微生物乐园,皮肤上的细菌种类多达数百种,数量更是以亿计。多数情况下,这些细菌与人类和平共处,甚至能帮助维持皮肤微生态平衡。但在特定场景下,比如睡前不注意清洁、接触污染物品后,有害细菌的数量会急剧增加,进而引发皮肤感染、呼吸道疾病等问题。
一、身体表面的“藏菌重灾区”
(一)手部:细菌的“移动载体”
手部是人体接触外界最频繁的部位,门把手、电梯按钮、手机、键盘等都可能成为细菌的传播媒介。
1、核心细菌种类
手部常见革兰氏阴性菌包括大肠埃希氏菌、肺炎克雷伯菌、铜绿假单胞菌。大肠埃希氏菌多来自粪便污染,易藏在指甲缝;肺炎克雷伯菌生命力强,干燥表面可存活数天;铜绿假单胞菌偏好潮湿环境,洗手后未擦干易滋生。

图1 大肠埃希氏菌在TSA平皿上
革兰氏阳性菌中,表皮葡萄球菌是皮肤常驻菌,皮肤破损时可能引发感染;金黄色葡萄球菌是典型致病菌,可通过手鼻接触传播,代谢毒素会引发毛囊炎、麦粒肿,严重时导致全身感染。
图2 金黄色葡萄球菌在TSA平皿上
手部还可能携带白色念珠菌等真菌,多来自潮湿环境或发霉物品,繁殖后会引发手癣,出现瘙痒、脱皮等症状。

图3 白色念珠菌在SDA平皿上
2、睡前风险隐患
睡前不洗手,细菌会通过揉眼睛、摸口鼻侵入人体,引发结膜炎、感冒、腹泻等;还会转移到脸部、枕头等部位,形成交叉感染。
(二)脸部:脆弱皮肤的“隐形威胁”
脸部皮肤薄且敏感,皮脂腺、汗腺丰富,分泌的油脂、汗液与角质层为细菌提供营养。白天化妆或长期处于户外、空调房,会让脸部细菌数量显著增加。
1、核心细菌种类
痤疮丙酸杆菌是脸部核心细菌,作为厌氧菌藏在毛囊中,以皮脂为食。皮脂腺分泌旺盛、毛囊口堵塞时,其会大量繁殖引发炎症,形成痘痘、粉刺。
马拉色菌是常见真菌,依赖油脂生存,脸部油脂过多或皮肤屏障受损时会过度增殖,引发花斑癣、脂溢性皮炎,夜间密闭环境更利于其繁殖。
此外,脸部还可能携带链球菌、棒状杆菌。链球菌通过污染手部、共用毛巾传播,易引发化脓性感染;棒状杆菌多见于油脂丰富区域,会分解皮脂产生异味、加重毛孔堵塞。
2、睡前风险隐患
睡前不彻底清洁脸部(尤其带妆入睡),化妆品残留会堵塞毛孔,与细菌、油脂混合加重痘痘,还会破坏皮肤屏障;细菌转移到枕头后,会与螨虫协同刺激皮肤,形成恶性循环。
(三)头发:细菌与螨虫的“温床”
头皮分布大量皮脂腺、汗腺,油脂、汗液、灰尘与头皮屑构成细菌繁殖温床,每平方厘米头皮细菌可达数万至数十万。
1、核心细菌种类
马拉色菌是头皮优势菌群,占比超60%,以油脂为食,过度增殖会刺激头皮发炎,导致瘙痒、头皮屑增多,严重时引发脂溢性脱发,夜间头皮升温更利于其繁殖。
葡萄球菌也是头皮常见细菌,表皮葡萄球菌在头皮破损时引发感染;金黄色葡萄球菌会引发毛囊炎,严重时破坏毛囊影响头发生长。
此外,头皮还可能携带丙酸杆菌、链球菌,前者会加重炎症,后者多来自污染物品,易引发化脓性感染。
2、睡前风险隐患
睡前不洗头,头皮细菌、油脂、头皮屑会粘在枕头,成为螨虫食物来源,夜间共同刺激头皮加重问题,还可能破坏头皮生态;细菌掉落至脸部、颈部也会引发感染。
二、睡前接触物品:被忽视的“细菌中转站”
手机、眼镜、枕头等睡前接触物品,因长期接触人体、环境复杂,也是藏菌重灾区,细菌会通过接触传播危害健康。如《看不见的细菌温床》这篇文章所述,对于极易接触的物品,使用表面接触皿TSA表面接触皿检测出表面微生物的数量远超想象。
(一)手机:细菌密度超马桶圈的“隐形污染源”
手机使用频率极高,白天随身携带、夜间睡前使用,表面细菌密度远超马桶圈,每平方厘米可达数万细菌。
1、核心细菌种类
金黄色葡萄球菌是手机表面常见致病菌,来自手部与皮肤,在手机表面可存活数天,睡前用手机后摸脸、揉眼睛会引发感染。
大肠杆菌多来自污染的手部、桌面,在手机表面存活时间长,接触后未洗手进食、摸嘴会引发腹泻等消化道疾病。
此外,手机还可能携带肺炎克雷伯菌、铜绿假单胞菌及白色念珠菌,多来自环境污染物,会通过接触传播至人体。
2、睡前风险隐患
睡前用手机时,屏幕贴近脸部、眼睛,细菌直接接触引发炎症;手机产热与夜间密闭环境会加速细菌繁殖,放枕头边还会污染床品。
(二)眼镜:贴近眼部的“细菌载体”
戴眼镜人群需注意,镜框、镜片直接接触眼周皮肤,且日常放置环境复杂,易沾染大量细菌。
1、核心细菌种类
表皮葡萄球菌是眼镜表面常见细菌,来自脸部与手部,眼周皮肤破损或免疫力下降时,会引发眼睑炎、结膜炎。
金黄色葡萄球菌多来自污染手部,在眼镜表面存活久,贴近眼部会刺激黏膜引发炎症,严重时导致麦粒肿。
眼镜还可能携带链球菌、肺炎克雷伯菌及白色念珠菌,多来自环境污染或共用物品,会传播至眼部与脸部。
2、睡前风险隐患
睡前不清洁眼镜,细菌会持续刺激眼周皮肤与黏膜引发感染,还会转移到脸部、枕头,扩大污染范围。
(三)枕头与睡衣:睡眠中的“细菌温床”
枕头与睡衣直接贴合皮肤,人体分泌的油脂、汗液、皮屑会为细菌提供充足营养,成为细菌温床。
1、核心细菌种类
枕头细菌种类复杂,包括金黄色葡萄球菌、大肠杆菌等,还存在大量螨虫与真菌,部分来自人体,部分来自环境。螨虫排泄物与尸体会引发过敏,刺激皮肤与呼吸道。
睡衣细菌主要来自皮肤表面,长期不更换会积聚大量细菌与分泌物,夜间持续接触皮肤引发炎症、产生异味。
2、睡前风险隐患
枕头与睡衣上的细菌、螨虫会刺激皮肤引发瘙痒、炎症,还可能诱发过敏体质人群的呼吸道疾病,同时影响室内空气质量与睡眠质量。
三、如何科学防控,打造“无菌”睡眠环境
无需过度恐慌,通过科学清洁防护,就能有效减少细菌、降低感染风险,以下是实用建议。
睡前彻底清洁,洗手用洗手液搓揉不少于20秒,重点清洁指甲缝;洗脸选合适洁面产品,带妆人群需彻底卸妆;头发至少2-3天洗一次,出油多者可增加频率。
定期清洁物品,手机每天用酒精棉片擦拭;眼镜睡前清洁,定期洗眼镜盒;枕套2-3周清洗,枕头至少每月晾晒一次;睡衣每天换、每周洗,选透气材质。
保持环境干爽,睡前开窗通风10-15分钟;不在床上进食;选透气被褥并定期晾晒。
养成良好习惯,避免频繁摸脸、揉眼;不共用个人物品;便后及时洗手。
四、结语
细菌无处不在,但我们并非无计可施。睡前身体表面和接触物品上的细菌,虽然可能带来健康隐患,但只要我们养成良好的清洁和卫生习惯,就能有效防控风险,打造一个健康、安全的睡眠环境。睡眠是身体修复的关键,别让细菌成为阻碍,从今晚起养成良好习惯,安心入睡。
五、相关培养基的采购
球盟会(中国)网页版有适用于对物品表面进行表面微生物测定的各种接触皿产品,客户可根据实际情况和用途进行选用。
|
产品编号 |
产品名称 |
规格 |
产品说明及用途 |
|
HBPM003-21 |
10个/包 |
用于环境、器皿、设备和表面的无菌检测 |
|
|
HBPM0235 |
55mm*10 |
用于微生物培养 |
|
|
HBPM035-11 |
10个/包 |
主要用于表面微生物的测定 |
注:本文属海博生物原创,未经允许不得转载。
| 相关文章: |



